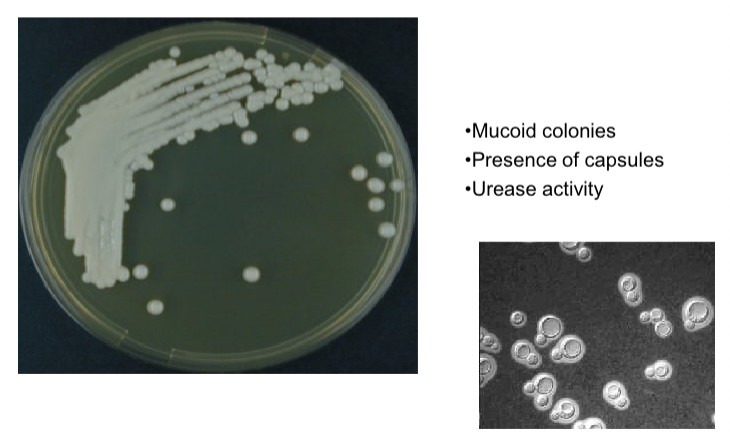
<p>Mucoid colonies, presence of capsules </p><p></p>

1/18
Looks like no tags are added yet.
Name | Mastery | Learn | Test | Matching | Spaced |
|---|
No study sessions yet.
Structure
Unicellular, round or oval organisms
What kind of reproduction
Asexual reproduction by budding
Produces blastoconidia

Blastoconidia can bud from
a - mother cell, b - hyphae, c - pseudohyphae

What are the names of genera
Candida albicans, Cryptococcus neoformans, Malassezia pachydermatis
Cultures of all
SDA aerobically 37
Candida albicans are ___morphic
Polymorphic (pseudohyphae, true septate hyphae and budding yeast cells)

What are the main virulence factors of candida albicans
Biofilm (make resistant to antifungals and immune system)
Phenotypic switching to adapt to host environment
What does candida albicans cause in dogs, cats, cows and horses
Dogs - enteritis, cutaneous lesions, mycotic stomatitis
Cats - cystitis, pyothorax, ocular lesions
Cows - abortions, mastitis, gastroesophageal ulcers, rumenitis
Horses - ulcers, pyometra, ocular lesions

What does candida albicans overall affect
Oral cavity, GI tract, urogenital tract
Microscopy candida albicans
See polymorphy

Cryptococcus neoformans shape
Round to oval cells
Daughter call are formed as bud

What is the main virulence factor of cryptococcus neoformans
Capsule → inhibit phagocytosis and suppressed immune response
Phenol oxidase —> accumulation of melanin for protection
What is the name of the condition caused by cryptococcus neoformans
Cryptococcosis
What does cryptococcosis cause in cats, dogs, cattle,horses
Cats - nasal swelling, sneezing, CNS signs (seizures, depression)
Dogs - ocular disease, CNS involvement
Cattle - mastitis and nasal granulomas
Horses - nasal granulomas, sinusitis, cutaneous lesions, pneumonia, abortion

Microscopy cryptococcus neoformans
Mucoid colonies, presence of capsules
Malassezia morphology
Bottle shaped, thick walled, monopolar budding

What does malassezia release
Lipase which alters oils, leading to irritation and inflammation
Can cause excessive ear wax and tissue damage in ears
What does malassezia pachydermatis cause in cats and dogs
Dogs - otitis externa (head shaking, discharge, inflammation), seborrheic dermatitis (greasy coast and foul odor)
Cats - feline chin acne, dermatitis

Microscopy malassezia pachydermatis
Use of methyl bue and gram stain to see yeast cells
